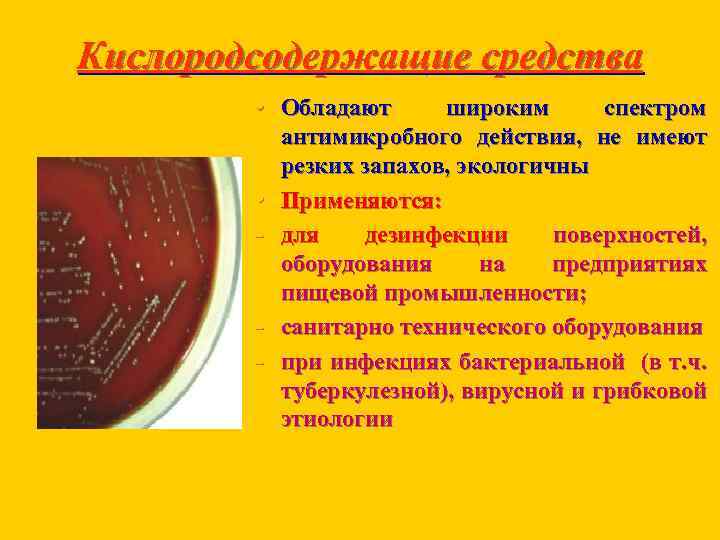
Кислородсодержащие средства • Обладают • - широким спектром антимикробного действия, не имеют резких запахов,
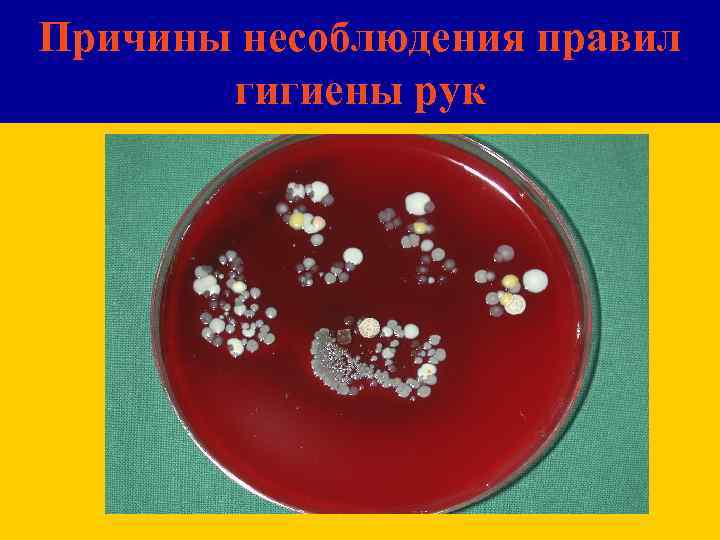
Причины несоблюдения правил гигиены рук
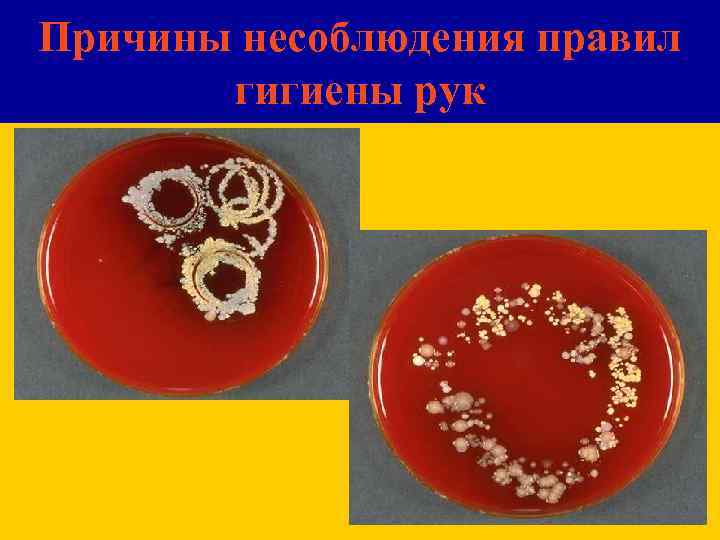
Причины несоблюдения правил гигиены рук
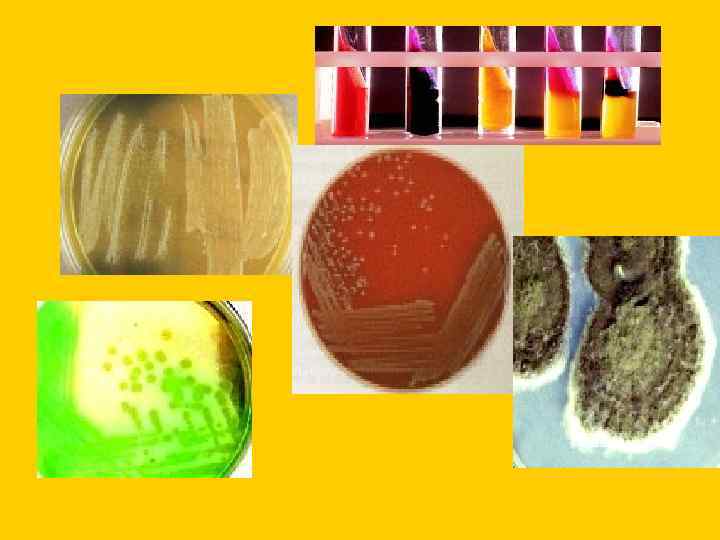

дезинфекция на пищевом предп..ppt
- Количество слайдов: 175

ДЕЗИНФЕКЦИЯ ДЕЗИНСЕКЦИЯ ДЕРАТИЗАЦИЯ

• Закон Республики Беларусь «О санитарно эпидемическом благополучии населения» (в ред. Законов Республики Беларусь от 23. 05. 200 № 397 3, от 29. 06. 2003 № 217 3, от 16. 05. 2006 № 109 3) Статья 1 Санитарные нормы, правила и гигиенические нормативы – технические нормативные правовые акты, устанавливающие критерии и требования к безопасности для человека факторов среды его обитания, санитарно гигиенические и противоэпидемические требования по обеспечению благоприятных условий его жизнедеятельности

Закон Республики Беларусь «О санитарно эпидемическом благополучии населения» (в ред. Законов Республики Беларусь от 23. 05. 200 № 397 3, от 29. 06. 2003 № 217 3, от 16. 05. 2006 № 109 3) • Статья 8 Санитарные правила обязательны для соблюдения государственными органами, иными организациями, физическими лицами, в том числе индивидуальными предпринимателями

• Статья 19. Обязанности организаций и индивидуальных предпринимателей в области обеспечения санитарно эпидемического благополучия населения • Организации и индивидуальные предприниматели в соответствии с осуществляемой ими деятельностью обязаны: осуществлять санитарно гигиенические и противоэпидемические мероприятия, направленные на предупреждение и ликвидацию загрязнения среды обитания человека, оздоровление условий труда, быта и отдыха населения, на улучшение условий воспитания и обучения детей, предупреждение возникновения и распространения заболеваний;

Закон Республики Беларусь «О санитарно эпидемическом благополучии населения» Статья 50 • За нарушение санитарного – эпидемиологического законодательства виновные лица привлекаются к ответственности в соответствии с законодательными актами Республики Беларусь

ДЕЗИНФЕКЦИЯ • Объединение мероприятий, проводимых по • дезинфекции, дезинсекции и дератизации, под одним понятием "дезинфекция" произошло давно Главной задачей дезинфекции является разрыв механизма передачи возбудителей инфекций на путях их передачи, в которых принимают участие членистоногие и грызуны

дезинфекция • Дезинфекция (или обеззараживание) обеспечивает умерщвление патогенных и условно патогенных микроорганизмов, являющихся возбудителями инфекций

дезинфекция • Дезинсекция обеспечивает умерщвление членистоногих, являющихся или возбудителями инфекций, или переносчиками, или резервуаром возбудителей инфекций

дезинфекция • Дератизация обеспечивает умерщвление грызунов, являющихся или переносчиками, или резервуаром, или источником возбудителей инфекции

ДЕЗИНФЕКЦИЯ • Завершающий процесс санитарной обработки на пищевых предприятиях • Совокупность мероприятий, направленных на уничтожение или снижение численности популяций вегетативных форм патогенных и условно патогенных микроорганизмов на поверхностях объектов внешней среды и оборудовании с целью профилактики инфекционных заболеваний

МЕТОДЫ ДЕЗИНФЕКЦИИ Механический Физический Химический

МЕТОДЫ ДЕЗИНФЕКЦИИ • Механический удаление микроорганизмов с объектов или их обеззараживание путем встряхивания, протирания, проветривания, вентиляции, стирки, мытья, очистки

МЕТОДЫ ДЕЗИНФЕКЦИИ • Физический обеззараживание воздействия физических • • путем агентов: ультрафиолетового облучения сухого горячего воздуха водяного пара кипячения

МЕТОДЫ ДЕЗИНФЕКЦИИ • Химический уничтожение микроорганизмов с помощью химических веществ на поверхностях, внутри объектов, в воздухе, в различных субстратах

ОСНОВНЫЕ ТРЕБОВАНИЯ К ДЕЗИНФИЦИРУЮЩИМ ПРЕПАРАТАМ • • • Широкий спектр антимикробной активности Безопасность применения Совместимость с обрабатываемыми материалами Экономичность Уровень устойчивости к органической нагрузке Скорость действия (требуемая экспозиция) Приемлимый запах Отсутствие воспламеняемости и взрывоопасности Простота в приготовлении, применении, удалении Экологичность

КЛАССИФИКАЦИЯ ДЕЗИНФИЦИРУЮЩИХ СРЕДСТВ • С учетом возможности поступления химических веществ в организм человека наиболее опасным путем — ингаляционно, для дезинфицирующих средств разработана классификация степени опасности • Она позволяет четко соблюдать определенные условия при их применении и меры предосторожности проведении дезинфекции .

Степень токсичности и опасности зависит от: • 1 состава рецептур • 2 рабочих концентраций • 3 времени воздействия За лимитирующий параметр токсичности принят порог острого действия

КЛАССИФИКАЦИЯ ДЕЗИНФИЦИРУЮЩИХ СРЕДСТВ Классификация ингаляционной опасности дезинфицирующих средств содержит 4 класса в соответствии с величиной зоны острого токсического действия

Дезинфицирующие средства применяются согласно инструкции производителя, согласованной МЗ РБ по следующим режимам: • Бактерицидный • • • обеспечивает уничтожение вегетативных форм бактерий, кроме возбудителя туберкулеза Применяется для дезинфекции: Поверхностей не имеющих загрязнений биологическим материалом При регистрации случаев инфекционных заболеваний бактериальной природы (шигеллезы, сальмонеллезы, дифтерия, скарлатина и др. )

Дезинфицирующие средства применяются согласно инструкции производителя, согласованной МЗ РБ по следующим режимам: • Вирулицидный • • • обеспечивает уничтожение вирусов Применяется для дезинфекции: Поверхностей, имеющих загрязнения биологическим материалом При регистрации заболевания вирусной этиологии (энтеровирусная инфекция, полиомиелит, вирусные гепатиты, в период эпидемического подъема заболеваемости гриппом)

Дезинфицирующие средства применяются согласно инструкции производителя, согласованной МЗ РБ по следующим режимам: • - Фунгицидный – обеспечивает уничтожение • грибов Применяется для дезинфекции поверхностей при подозрении или подтверждении диагноза заболеваний грибковой этиологии, обработке «влажных» объектов в душевых, ванных комнатах, санитарных пропускниках

Дезинфицирующие средства применяются согласно инструкции производителя, согласованной МЗ РБ по следующим режимам: • -Туберкулоцидный • обеспечивает уничтожение возбудителя туберкулеза Применяется для поверхностей в противотуберкулезных учреждениях, при подозрении или подтверждении диагноза активного туберкулеза

Дезинфицирующие средства применяются согласно инструкции производителя, согласованной МЗ РБ по следующим режимам: • - Спороцидный обеспечивает уничтожение • вегетативных и споровых форм бактерий, вирусов, грибов Применяется для поверхностей по показаниям при регистрации случаев инфекции, вызванной анаэробной микрофлорой и т. д.

Современное дезинфицирующее средство • Представляет собой композицию на основе сбалансированной формулы, включающей одно или несколько активно действующих веществ (АДВ) в соотношениях, позволяющих добиться максимального синергизма или потенцирования эффекта в отношении наиболее устойчивых микроорганизмов

ВСПОМОГАТЕЛЬНЫЕ КОМПОНЕНТЫ 1. 2. 3. 4. 5. 5. 6. Ингибиторы коррозии Комплексообразователь Регуляторы р. Н Моющий комплекс Энзимы Краситель Отдушка и др.

КЛАССИФИКАЦИЯ ДЕЗИНФИЦИРУЮЩИХ СРЕДСТВ

Галоидсодержащие вещества • - Соединения имеющие в своем составе в качестве АДВ хлор, бром, йод Спектр противомикробного действия: активны в отношении спор микобактерий туберкулеза вирусов (СПИДа, вирусного гепатита В, ОРВИ)

Галоидсодержащие вещества • Применяются для: - дезинфекции помещений - обработки с/т оборудования уборочного инвентаря, посуды

Классификация галоидов

Хлорсодержащие вещества разделяют на 2 большие группы: • неорганические соединения хлора • органические соединения хлора

Хлорсодержащие вещества Положительные свойства: • • • Высокая активность Широкий спектр антимикробного действия Дезодорирующие, отбеливающие свойства Гомогенизирующая способность Низкая стоимость Быстрота действия

Хлорсодержащие вещества Недостатки: • Плохая, • • • недостаточная или полная нерастворимость у ряда соединений Низкая стабильность Необходимость постоянного контроля содержания активного хлора в рабочих растворах в должной концентрации Короткий срок хранения рабочих растворов

Хлорсодержащие вещества • Вызывают коррозию металлов, проблемы в • • комбинировании с детергентами Инактивируются органическими соединениями Могут отбеливать ткани Потенциальная канцерогенность при контакте с формальдегидом В сточных водах не разлагаются, а образуют устойчивые галогенорганические соединения, представляющие опасность (канцерогенны, мутагенны, тератогенны)

Хлорсодержащие вещества Недостатки: – Низкая активность некоторых из них (например, хлорамина) в отношении устойчивых видов микроорганизмов — микобактерий туберкулеза, грибов, спор, бацилл, что зачастую приводит к необходимости активации рабочих растворов перед их применением

Хлорамин • Белый кристаллический порошок, хорошо растворяется в воде, при правильном хранении за год теряется только 0, 1— 0, 2% активности препарата • Хлорамин используется: в сухом виде в виде растворов

Кислородсодержащие средства • ДВ кислород в составе перекиси • водорода, перекисных соединений, надкислот Традиционно применяют перекиси водорода и комбинированные препараты, содержащие перекисные соединения или перекись водорода с различными добавками
Кислородсодержащие средства • Обладают • - широким спектром антимикробного действия, не имеют резких запахов, экологичны Применяются: для дезинфекции поверхностей, оборудования на предприятиях пищевой промышленности; санитарно технического оборудования при инфекциях бактериальной (в т. ч. туберкулезной), вирусной и грибковой этиологии

Кислородсодержащие средства Перекись водорода (достоинства) • Широкий спектр активности против • • • микроорганизмов, включая споры Не требует активации Может способствовать снятию органического загрязнения Без запаха, нетоксична Безопасность для окружающей среды Легко удаляется

Кислородсодержащие средства Перекись водорода (недостатки) • При попадании в глаза может вызывать • ожоги Обладает обесцвечивающим эффектом и несовместима с такими металлами как латунь, цинк, медь, никель, серебро

Надкислоты • • (средства на основе надмуравьиной и надуксусной кислот) Широкий спектр активности против микроорганизмов, включая споры Легко смешиваются с водой и спиртом Обладают сильными окислительными свойствами Быстро действуют при низких концентрациях и температурах Эффективность в присутствии органических материалов Не требует активации Совместима со многими другими дезинфектантами

Надкислоты (средства на основе надмуравьиной и надуксусной кислот) • Дорогостоящие • Концентрат может вызвать ожоги кожи и • слизистых Нестабильны

Альдегидсодержащие средства • Группа препаратов, действующим началом которых является глутаровый или ортофталевый альдегид Формальдегид (альдегид муравьиной кислоты) — бесцветный газ с удушливым запахом, обладающий сильными раздражающими свойствами для слизистых оболочек дыхательных путей и глаз

Альдегидсодержащие средства Формальдегид хорошо растворим в воде и - выпускается в виде 40% водного раствора (формалин) Применяют: для обеззараживания вещей в дезинфекционных камерах стерилизации «холодным методом» в газовых стерилизаторах, для изделий, изготовленных из термолабильных материалов

Альдегидсодержащие средства (достоинства) • Широкий спектр активности, включая споры • отсутствие или низкая коррозионная • • • активность в отношении металлов отсутствие резких запахов (за исключением формалина) стабильны обладают хорошей проникающей особенностью, быстрой разрушаемостью в сточных водах

Альдегидсодержащие средства Глутаровый альдегид - Не повреждает изделия из резины, металлов - Эффективен в присутствии органических - материалов Нестабилен Высокая стоимость Нуждается в активации Может вызвать ожоги кожи и слизистых Фиксирует белковые загрязнения

Альдегидсодержащие средства - Формальдегид Не требует активации Потенциально канцерогенное действие Резкий запах, раздражающее действие Требует нейтрализации

Дезинфектанты и стерилянты на основе глутарового альдегида были и остаются «золотым стандартом»

Гуанидины • Действующим • • • началом препаратов этой группы являются сложные органические соединения Гуанидины активны в отношении грамположительных и грамотрицательных микроорганизмов (за исключением микобактерий туберкулеза) Не проявляют активности к вирусам, грибам, спорам Расширение спектра антимикробной активности происходит при сочетании с ПАВ

Гуанидины • Применяются для низкого и среднего уровня • • • обработки поверхностей, проведения текущей уборки Малотоксичные соединения с пролонгированным действием Для обработки любых материалов, посуды, текстиля и т. д. Пример – препарат «Полидез»

Спирты Группа препаратов на основе этанола, пропанола, изопропанола • Наиболее высоким бактерицидным и вирулицидным действием обладает этиловый спирт, который используется для обеззараживания рук и других объектов

Спирты 70% спиртовой раствор: 70 мл 96% спирта + 26 мл воды

Спирты • 70% раствор обладает свойствами: бактерицидным (кроме спор) вирулицидным (включая вирусы ВИЧ и гепатитов) • Фиксирует органические загрязнения

Спирты • • Растворы и аэрозоли на основе спиртов с добавками, расширяющими спектр их антимикробной активности, применяются: для обработки поверхностей, помещений, мебели, оборудования для обработки санитарно технического оборудования, уборочного инвентаря, посуды, обеззараживания выделений

Спирты • Кожные антисептики • на основе спиртов в сочетании с другими добавками являются готовыми к применению препаратами Их используют для обеззараживания кожи рук персонала

ГИГИЕНА РУК

Гигиена рук Состояние проблемы 1. 3. Отсутствие четких рекомендаций 2. Недостаточные ресурсы Недостаточное соблюдение требований гигиены рук

Недостаточные ресурсы

Внимание, Пользоваться только бумажными полотенцами! Пеленки не брать

Причины несоблюдения правил гигиены рук
Причины несоблюдения правил гигиены рук

Причины несоблюдения правил гигиены рук • 61% забывчивость • 42% недостаток знаний • 35% недостаток • • времени 22% проблемы с кожей 17% недостаточное осознание проблемы • 8 11% забывчивость • 36 39% недостаток • • • Mein Hand sind sauber/Warum soll ich sie Dezinfizieren? Mhp Verlag Gmb. H Wiesbaden 1996 • времени 15 30% проблемы с кожей 11% недостаточное осознание проблемы 50 85% экстренная ситуация 20 35% отсутствие средств и условий Санкт Петербург, 2001

Факторы, обусловливающие плохое соблюдение гигиены рук, о которых сообщили самостоятельно 1. 2. 3. 4. 5. 6. 7. 8. 9. 10. 11. 12. 13. 14. Средства для мытья рук вызывают раздражение и сухость Мойки расположены неудобно/моек не хватает Нехватка мыла, полотенец и т. д. Часто слишком большая занятость/нехватка времени Нехватка персонала/переполненность отделения Прежде всего следует уделять внимание пациентам Невысокий риск заражения от больного Ношение перчаток убеждение в том, что при ношении перчаток мыть руки необязательно Недостаточное знание инструкций Не думают об этом/забывают Нет положительного примера коллег или руководства Скептическое отношение Несогласие с рекомендациями Отсутствие научной информации о положительной связи между тщательным соблюдением гигиены рук и частотой внутрибольничных инфекций.

Результаты опроса / Результаты наблюдения мыло антисептик перчатки



Идеальный метод: • Не должен требовать много времени • Должен уменьшать загрязнение рук до максимально низкого уровня • Не должен обладать существенным побочным воздействием на кожу рук медицинского персонала

Ранжирование требований по степени их обоснованности Не доливать мыло к частично использованному в дозатор. Эта практика может привести к бактериальной контаминации мыла IА.

Ранжирование мероприятий по степени их обоснованности Если явное загрязнение рук отсутствует, следует проводить гигиеническую антисептику рук с помощью безводного (спиртового антисептика) 1 А

Гигиена рук работников Ø Ø Ø мытье рук антисептика рук косметический уход за кожей рук

Профилактика профессионального дерматита Персонал должен быть обеспечен лосьонами или кремами для снижения риска возникновения контактных дерматитов, связанных с мытьём и антисептикой рук

Результаты обработки рук Удаление транзиторной флоры Уменьшение количества резидентной флоры Уменьшение вероятности перехода транзиторной флоры в резидентную


Гигиеническое мытье рук Цель: • удаление грязи и транзиторной флоры, контаминирующей кожу рук

Гигиеническое мытье рук Показания: после посещения туалета перед контактом с пищевыми продуктами или продукцией, контактирующей с пищей, приготовлением и раздачей пищи, перед едой во всех случаях, когда руки явно загрязнены, в т. ч. биологическими жидкостями после снятия неповреждённых перчаток перед выполнением антисептики кожи рук

Доля неудовлетворительных проб на стерильность, взятых после предоперационной обработки рук хирургом А. тыльная поверхность В. ладонная поверхность


Рекомендуемая техника мытья рук: • Снять кольца, перстни и другие украшения, • • • поскольку они затрудняют эффективное удаление микроорганизмов. Под умеренной струей комфортно теплой воды руки следует энергично намылить и тереть друг о друга не менее 10 секунд, соблюдая технику, после чего сполоснуть. Следует помнить, что наиболее часто пропускаемые места – большие пальцы и тыльные поверхности пальцев и кистей рук. Высушить руки бумажным полотенцем, которым затем закрыть кран.


Техника обработки рук


Критерии выбора мыла • • • Приемлeмость персоналом Тип упаковки или дозатора Частота аллергических реакций Частота возникновения дерматита Стоимость

Антисептика рук Применение химических веществ, обладающих антимикробным действием и предназначенных для использования на коже или других поверхностных тканях организма человека для деконтаминации рук

Гигиеническая антисептика рук Цель: удаление или уничтожение транзиторной микрофлоры рук

Рекомендуемая техника гигиенической антисептики: 3 5 мл спиртового антисептического раствора следует нанести на руки и втирать, соблюдая технику, до высыхания (вытирать руки не следует). Важно соблюдать время воздействия: руки должны быть влажными от антисептика не менее 15 сек

Использование перчаток Перчатки могут в некоторых случаях давать работникам ложное чувство безопасности, ведущее их к пренебрежению мытья рук. Руки могут быть контаминированы через перчатки или при их снятии. При частом использовании перчаток, или при их длительном ношении, микробная флора, живущая под ногтями может мигрировать и контаминировать руки и перчатки.

Использование перчаток • • • Никакие перчатки не являются 100% непроницаемыми для микробов (по различным данным проницаемыми оказались 4 63% исследованных виниловых перчаток и 3 52% латексных). Проникновение жидкости внутрь перчаток отмечалось для виниловых перчаток – в 43%, для латексных – в 9%. Принятые методы обработки перчаток многократного применения снижают их защитные свойства, причем значительно быстрее, чем это указано в паспорте производителя

Какие перчатки выбрать? • • Необходимый размер Характер выполняемой манипуляции Время использования перчаток Аллергические реакции в анамнезе Толщина и эластичность материала перчаток Минимизация потовыделения Использование дополнительной пары перчаток уменьшает частоту повреждений при работе с острыми инструментами в 2 4 раза(Cohen M. S. et al. , 1992)

Какие перчатки выбрать? • Прилегание к руке должно быть полным на • • протяжении всего времени их использования Не должны вызывать утомление рук Должны быть надежными при «острых» ситуациях (работа с колюще режущими инструментами) Должны сохранять хорошую тактильную чувствительность Минимальное содержание антигенных белков

Использование перчаток не заменит хорошую технику мытья рук, которое должно быть выполнено после снятия перчаток

Пути совершенствования процедуры обработки рук • Достичь и в дальнейшем поддерживать здоровое • • • состояние кожи Обеспечить наличие адекватных растворов Представить научное обоснование, показания и методы обработки рук Обеспечить доступность санузлов и других необходимых предметов Следить за соблюдением должной рабочей нагрузки Обеспечить максимальное удобство обработки рук


Фенолы - одни из первых дезинфектантов • Из за токсичности в чистом виде не • • используются Свет и влага не оказывают воздействия на бактерицидные свойства фенола В химическом отношении он является одним из самых стойких дезинфицирующих средств

Фенолы • Растворы фенола обладают сильным бактерицидным, фунгицидным и вирулицидньм действием • Спороцидным действием не обладают • Антимикробная активность фенола усиливается: при добавлении кислот, мыла, повышении Т раствора снижается в присутствии белков

Фенолы • Используется производное фенола – бифинол • Применение – для обеззараживания поверхностей, применяются в косметологии и технических сферах в качестве консервантов

Третичные амины • Совершенно новый тип дезинфектантов • Активны в отношении бактерий (включая • • микобактерии), грибов и вирусов Обладают невысокой токсичностью и хорошими моющими свойствами Стабильны, хорошо растворимы в воде, не повреждают обрабатываемые поверхности

Четвертичные аммониевые соединения (ЧАС) • Эффективны против некоторых вегетативных • • форм Актуальны для применения в пищевой промышленности Рабочие растворы малоопасны, применяются многократно до 16 дней Несовместимы с мылом из за щелочности Особенно интересны в сочетании с ЧАСами органические кислоты • Пример – дезинфектант «Дескоцид» для поверхностей и оборудования в пищевой отрасли

Поверхностно-активные вещества (ПАВ) • Подразделяются на: анионные (содержат отрицательно заряженные группы — SO 3 , ОРОз , СОО и др. ) катионные (амины) неионогенные (не диссоциируют на ионы в водном растворе)

Поверхностно-активные вещества (ПАВ) • Значительным преимуществом препаратов этой группы, наряду с моющими свойствами, является отсутствие резких запахов и низкий уровень токсичности

Поверхностно-активные вещества (ПАВ) Предостережение! • Следует осторожно выбирать препараты этой группы вследствие их достаточно узкого антивирусного и ограниченного антимикробного спектра действия и полного отсутствия спороцидного эффекта

Поверхностно-активные вещества (ПАВ) Обладают: • стабильностью • хорошими моющими свойствами • щадящим действием на обрабатываемые объекты • низкой токсичностью

Поверхностно-активные вещества (ПАВ) • Одновременно • характеризуются антимикробного избирательностью действия В связи с чем большинство из них неактивны/ малоактивны в отношении устойчивых видов и форм микроорганизмов — микобактерий туберкулеза, грибов, спор, бацилл

Поверхностно-активные вещества (ПАВ) • • Жидкие концентраты ПАВ с высоким содержанием ДВ обладают: выраженным резорбтивным и раздражающим действием на кожу и слизистые оболочки глаз часто являются аллергенами

Поверхностно-активные вещества (ПАВ) • Полимерные • ПАВ образуют на поверхностях обработанных объектов трудноудаляемую пленку, фиксируют органические вещества При комбинации ПАВ с альдегидами и спиртами дезинфицирующие свойства препаратов данной группы усиливаются!

В мире существуют определенные тенденции в выборе активных соединений для дезинфектантов • Наиболее • • широко распространены композиционные препараты, разработанные на основе альдегидов, катионных ПАВ, спиртов, ЧАС В качестве новых разработок появляются препараты, изготовленные на основе стабилизированной перекиси водорода, надкислот, третичных аминов Рецептуры на основе галогенов и фенолов (за исключением бифинилола) постепенно выходят из применения

технология и культура производства • Качество продукции пищевого предприятия это комплексная проблема, определяемая рядом факторов, которые объединяются понятием "технология и культура производства". • Одним из наиболее опасных источников микробной • контаминации является загрязненное или недостаточно отмытое оборудование. Главным критерием при выборе моющих и дезинфицирующих средств должна быть эффективность взаимодействия с загрязнениями, в зависимости от вида и характера их связей с поверхностями, на которых они образуются.

• Основная масса загрязнений оборудования находится в виде макрочастиц белково жирового комплекса и гелеобразных отложений, связанных с поверхностью (на поверхности молокопроводов, танков, в твороженных и сырных ваннах и т. д. ) • Эти загрязнения образуются в результате физико-механического воздействия на продукт

• Особенностью загрязнений этого вида • является то, что силы связи внутри загрязнений ниже адгезионных (между загрязнением и поверхностью), и они увеличиваются по мере приближения к поверхности Этим загрязнениям присуща кажущаяся легкость их удаления визуально поверхность выглядит чистой

АДГЕЗИЯ (прикрепление) БАКТЕРИЙ

• Для каждой отрасли промышленности • присущи свои особенности и специфика обрабатываемых объектов • В последнее время на пищевых предприятиях все чаще используют перекисные дезинфекционные средства, что определяется их высокими потребительскими свойствами В основном это препараты на основе стабилизированной перекиси водорода и надуксусной кислоты

Грам + бак. Глютаровы й альдегид Глиоксаль Спирты Фенольные дериваты Четвертич. аммонийны е соединения Гуанидины Тензиды Перекисные соединения Йод Грам бак. Гриб ы Микобак- Вирусы с терии оболочкой Вирусы с оболочкой Споры

СПЕКТР АНТИМИКРОБНОЙ АКТИВНОСТИ ДЕЙСТВУЮЩИХ ВЕЩЕСТВ ДЕЗИНФЕКТАНТОВ

МЕХАНИЗМЫ МИКРОБИОЛОГИЧЕСКОЙ АКТИВНОСТИ ДЕЗИНФЕКЦИОННЫХ СРЕДСТВ РАЗЛИЧНЫХ ГРУПП РЕЗИСТЕНТНОСТЬ – АДАПТАЦИЯ – ТОЛЕРАНТНОСТЬ МИКРООРГАНИЗМОВ

Существуют два основных механизма резистентности: üприродная резистентность, как естественное свойство микроорганизма ü приобретенная резистентность

ЕСТЕСТВЕННАЯ РЕЗИСТРЕНТНОСТЬ МИКРООРГАНИЗМОВ * Прионы (CJD, BSE) Coccidia (Cryptosporidium) Споры (Bacillus, C. difucile) Микобактерии (M. tuberculosis, M. avium) Цисты (Giardia) Малые безоболочечные вирусы (Polio virus) Трофозоиты (Acanthamoeba) Грамотрицательные бактерии (Pseudomonas, Providencia) Плесневые грибы (Aspergillus) Дрожжевые грибы (Candida) Большие безоболочечные вирусы (Adenovirus) Грамположительные бактерии (S. aureus, Enterococcus) Вирусы с липидной оболочкой (HIV, HBV)

Виды адаптации микроорганизмов • Физиологическая (фенотипическая) - споруляция - биопленка • Генотипическая - плазмиды (эписомальные, интегрированные в генофор) - транспозоны (Тn-элементы) - μ-бактериофаг - активация неактивных зон генофора

Физиологическая (фенотипическая) адаптация Ассоциация микроорганизмов с твердыми поверхностями приводит к образованию биопленки, определяемой как объединение организмов, организованных в пределах обширного экзополисахаридного экзополимера. Биопленки могут состоять из монокультур, из нескольких разных видов или из смешанных фенотипов различных видов. Биопленки являются причиной : - биокоррозии, - ухудшения качества воды - загрязнения гигиенических продуктов - колонизация имплантированных биоматериалов и медицинских приборов может быть возможной причиной вторичной инфекции, часто приводит к возрастанию скорости распространения инфекции и угрозы генерализации инфекционного процесса.

Биопленка хорошо организованное, взаимодействующее сообщество микроорганизмов • Является агрегатным состоянием для вегетативным форм, особенно при неблагоприятных условиях

БИОПЛЕНКИ СТРУКТУРИРОВАННОЕ СООБЩЕСТВО БАКТЕРИАЛЬНЫХ КЛЕТОК, ЗАКЛЮЧЕННОЕ В ПОЛИМЕРНЫЙ МАТРИКС И ПРИКРЕПЛЕННОЕ К ИНЕРНТНЫМ ИЛИ ЖИВЫМ ПОВЕРХНОСТЯМ

Предвестники формирования РОСТ БАКТЕРИЙ

Биопленка • Микроорганизмы • • • сгруппированы в микроколонии Они окруженные обволакивающим межмикробным матриксом Имеют свои микросреды, отличающиеся уровнями р. Н, усваиваемостью питательных веществ, концентрациями кислорода Бактерии в биопленке общаются между собой посредством химических раздражений (сигналов)

Биопленка развивается из свободно плавающих бактерий, которые затем прикрепляются к поверхности и посредством межклеточных коммуникаций образуют колонии, состоящие из микроорганизмов и внеклеточного вещества. Эти структуры допускают циркуляцию жидкости, которая доставляет питательные вещества и удаляет отходы. Иллюстрация Joan Kozol, Университет Висконсина в Медисоне, Отдел медицинских иллюстраций

Биопленка • Микроорганизмы в биопленке устойчивы к дезинфектантам, в особенности, «пленочным» , на основе бигуанидов и четвертичных аммонийных соединений

Поверхность биопленки Основа биопленки Связь с субстратом Субстрат Перепанова Т. С. НИИ Урологии МЗ РФ, 2003

ЛОКАЛИЗАЦИЯ БИОПЛЕНОК Все известные твердые поверхности (камни, песок на дне водоема, трубы нефтепровода, молокопровода и т. д. )

МИКРООРГАНИЗМЫ, ФОРМИРУЮЩИЕ БИОПЛЕНКИ - СЕМЕЙСТВO ENTEROBACTERIACEAE -STAPHYLOCOCCUS spp. , -STREPTOCOCCUS spp. , -ENTEROCOCCUS spp. , -ACTINOMYCES spp. , -PSEUDOMONAS spp. , -HAEMOPHILUS spp.


УСЛОВИЯ, ОБЯЗАТЕЛЬНЫЕ ДЛЯ ФОРМИРОВАНИЯ БИОПЛЕНКИ 1. Влажная среда. Застойные явления или постоянный, однонаправленный поток жидкости. 2. Отсутствие механического очищения. 3. Длительный промежуток времени

Этапы формирования биопленки 1. Адгезия на поверхности 2. Образование слизистой (экзополисахаридной) капсулы вокруг микробной клетки 3. Прилипание других микроорганизмов к слизистой капсуле и (или) размножение исходной клетки Жидкость

Этапы формирования биопленки 4. Построение биопленки 5. Отрывание фрагмента биопленки под влиянием механических факторов Поток жидкости →→

Транспорт бактерий Предвестники формирования биопленки Адгезия бактерий Рост бактерий

Физиологическая (фенотипическая) адаптация Бактерии в различных частях пленки имеют различный доступ к питательным веществам, и это влияет на их физиологические свойства. • В глубине биопленки, например, ограничение в питательных веществах, уменьшает скорость роста бактерий, что может повлиять на чувствительность к антимикробным агентам. • Таким образом, фенотипы собравшихся внутри пленки микроорганизмов значительно отличаются от планктонных клеток, обнаруживаемых в лабораторных культурах. • Медленно растущие бактерии являются особенно нечувствительными. • Бактерии, удаленные из биопленки и рекультивированные в культуральной среде в целом не являются более резистентными, чем "обычные" планктонные клетки этих видов.


Причины пониженной чувствительности бактерий в биопленке: 1) пониженный доступ дезинфицирующего вещества в 2) 3) 4) 5) клетки внутри биопленки, химическое взаимодействие между дезинфицирующим веществом и самой биопленкой (матриксом); изменения микроокружения; выработка разрушающих ферментов (и нейтрализующих химических веществ) в микроорганизмах и матриксе; генетический обмен между клетками в биопленке.

• 1. 2. 3. Устойчивость биопленки к обычным методам химической дезинфекции Биопленки устойчивы к действию антимикробных агентов благодаря использованию различных механизмов: Связывание и инактивация биоцидных веществ компонентами слизистого внеклеточного матрикса Плохое проникновение биоцидных веществ через слой биопленки Часть популяции бактерий имеет устойчивый фенотип/физиологическое состояние

Биопленка на внутренней поверхности трубопроводов

Биопленка • Тщательная очистка, обезжиревание поверхностей, особенно шероховатых, поврежденных – основа эффективной дезинфекции

Применение дезинфектантов • На • • • эффективность действия дезинфектантов оказывает влияние не только вид бактерий, но и их количество Ни о каком дезинфектанте нельзя сказать с уверенностью, что он уничтожит все имеющиеся бактерии Полное уничтожение почти невозможно Уничтожение 99, 9% признается адекватным

КОНТРОЛЬ КАЧЕСТВА ДЕЗИНФЕКЦИИ • Контроль проводят методами : • визуальным • бактериологическим • и химическим

Уровни дезинфекции Высокий Туберкуло цидное действие Средний Низкий Вирули цидное действие Бактерицидное действие

Химический способ дезинфекции и факторы, влияющие на его эффективность: качество предшествующей очистки • концентрация дезинфектанта • тип и концентрация микробной контаминации • время контакта дезинфицируемой поверхности с дезинфицирующим агентом • физические и химические факторы окружающей среды (наличие растворимого кальция или магния в воде повышает ее жесткость и способствует нейтрализации дезинфектанта, повышение температуры ускоряет действие дезинфектанта) • наличие биопленок на обрабатываемом объекте •

Двухэтапный процесс Очистка Дезинфекция Очистка удаляет большинство бактерий, а оставшиеся доступны дезинфектантам

• Эффективная дезинфекция возможна • • • только при тщательной подготовке поверхностей Требуется предварительная тщательная очистка Ее отсутствие лежит в основе формирования биопленок Биопленки представляют серьезную проблему в пищевой отрасли, при производстве лекарственных средств

ДЕЗИНСЕКЦИЯ И ДЕРАТИЗАЦИЯ

Дезинсекция • Термин дезинсекция был впервые предложен • • • в 1909 для обозначения мероприятий по уничтожению насекомых — переносчиков заразных болезней Членистоногие являются наиболее многочисленным типом отряда беспозвоночных Среди них встречаются как вредные, так и полезные виды К вредным относятся вредители сельского и лесного хозяйства, продуктов питания, переносчики заразных болезней животных и человека

дезинсекция • Многообразие условий, в которых осуществляется вредное действие членистоногих, определяет их экологические и биологические особенности и требует дифференцированного подхода к проведению мероприятий по борьбе с ними.

ВИДЫ ДЕЗИНСЕКЦИИ • очаговая и профилактическая дезинсекция. • Очаговая дезинсекция подразделяется на текущую и заключительную

МЕТОДЫ ДЕЗИНСЕКЦИИ • Разнообразие биологических особенностей отдельных видов членистоногих, а также условий их существования требует применения самых разнообразных способов борьбы с ними • В зависимости от природы используемых агентов различают три метода: • физический • химический • биологический

Дератизация • Система организационных, санитарнотехнических, санитарно-гигиенических и истребительных мероприятий, направленных на регулирование численности грызунов, осуществляемых с целью обеспечения санитарноэпидемиологического благополучия населения, создания благоприятных условий жизнедеятельности человека путем устранения или уменьшения вредного воздействия грызунов на человека.


Дератизация • Отряд грызунов является наиболее многочисленным • • • из класса млекопитающих К нему относится около трех тысяч видов, что составляет одну треть класса млекопитающих многие из видов грызунов являются важнейшими источниками инфекций и хранителями многих возбудителей инфекционных болезней Некоторые грызуны постоянно живут вблизи человека и могут быть эпидемиологически опасны для людей Более 60 видов грызунов формируют природные очаги инфекционных болезней, к которым восприимчив человек Кроме того, грызуны причиняют большой экономический ущерб


Дератизация • Многие виды грызунов играют основную роль в • • распространении ряда инфекционных болезней Особо опасны в этом плане крысы и мыши, так как они наиболее близко соприкасаются с жилищем человека, с предметами обихода, продуктами питания Оба эти вида грызунов обитают и размножаются практически во всех категориях строений и объектов (жилые дома, коммунальные объекты, промышленные предприятия, склад кие помещения, подземные коммуникации, объекты животноводства, хранилища фуража и т. д. )

• САНИТАРНЫЕ ПРАВИЛА ОБ ОРГАНИЗАЦИИ И ПРОВЕДЕНИИ МЕРОПРИЯТИЙ ПО УНИЧТОЖЕНИЮ ГРЫЗУНОВ, БЫТОВЫХ НАСЕКОМЫХ, КОМАРОВ ПОДВАЛЬНЫХ ПОМЕЩЕНИЙ 23. 08. 2002 N 54

ДЕЗИНСЕКЦИЯ И ДЕРАТИЗАЦИЯ • Наличие грызунов и насекомых на • эпидемически значимых объектах (пищевых, коммунальных и других) не допускается Присутствие грызунов и насекомых на данных объектах свидетельствует о санитарно-гигиеническом неблагополучии

ДЕЗИНСЕКЦИЯ И ДЕРАТИЗАЦИЯ • Все юридические и физические лица обязаны принимать меры по борьбе с грызунами и насекомыми в зданиях и сооружениях, принадлежащих на праве собственности или в арендуемых, предназначенных для трудовой деятельности людей, в наземных и подземных сооружениях, а также на прилегающих к ним территориях в пределах городских или сельских населенных пунктов, объектах сельскохозяйственного и промышленного производства, транспорта и коммуникаций

• Организации обязаны заключать договоры на проведение дератизационных и дезинсекционных работ


• В • • число обязательных мер по снижению численности грызунов и насекомых входят: санитарно технические мероприятия, направленные на поддержание чистоты на объектах: регулярный вывоз мусора соблюдение мер, предотвращающих заселение помещений грызунами и насекомыми, в т. ч. текущий ремонт, влажная уборка перед обработкой поверхностей с целью удаления следов пребывания насекомых при дезинсекции

• В число обязательных мер по снижению численности грызунов и насекомых входят: истребительные мероприятия против грызунов и насекомых, осуществляемые юридическими и физическими лицами, имеющими специальное разрешение (лицензию) на занятие данным видом медицинской деятельности

• Мероприятия по борьбе с грызунами и насекомыми направлены на обеспечение санитарно эпидемического благополучия населения и являются важными средствами: профилактики ряда инфекционных и аллергических заболеваний, распространяемых насекомыми (туляремия, гепатит, кишечные инфекции и другие; аллергии - ринит, дерматит, бронхиальная астма и другие), грызунами (чума, туляремия, лептоспироз, псевдотуберкулез, иерсиниоз, сальмонеллез и другие); поддержания необходимых гигиенических условий в жилых и производственных помещениях; устранения беспокоящего фактора, ухудшающего настроение, снижающего работоспособность населения

• Помещения и места в них, предназначенные • для хранения пищевых продуктов, подсобные помещения (особенно в пищевых организациях), подвалы, лестничные клетки, чердаки запрещается загромождать стройматериалами, тарой, непригодным оборудованием, посторонним инвентарем, мебелью, утилем и другими материалами, создающими укрытия для насекомых и грызунов и затрудняющими доступ к местам проведения дератизационных и дезинсекционных работ Их следует систематически убирать и ликвидировать загромождения

• Скоропортящиеся • • пищевые продукты должны храниться в холодильных камерах, холодильниках и других подобных устройствах, обеспечивающих недоступность продуктов для грызунов и насекомых В магазинах, складах, хранилищах и других аналогичных объектах все товары, продовольственное и сельскохозяйственное сырье должны храниться в таре, уложенными в штабеля, на стеллажах и подтоварниках на высоте не менее 25 см от пола На предприятиях по переработке пищевых и сельскохозяйственных продуктов эксплуатация транспортирующих и других механизмов должна исключать просыпание перерабатываемых и конечных продуктов

• Владельцам • • или арендаторам объектов (зданий, сооружений и других) следует обеспечивать для лиц, проводящих дератизацию и дезинсекцию, доступ к стенам, углам и техническим вводам. В складских помещениях необходимо устраивать постоянные проходы вдоль стен, между штабелями пищевых продуктов и других грузов через 5 6 метров, шириной не менее 70 см. Необходимо также (не реже 1 раза в 2 месяца) извещать организацию, проводящую дератизационные и дезинсекционные работы, о сроках полного или частичного освобождения складского помещения

• Сроки и способы проведения дезинсекционных мероприятий устанавливаются специалистами государственных санитарно эпидемиологических организаций, а дезинсекция в очагах инфекционных заболеваний после энтомологического обследования объекта

Администрация объекта обязана обеспечить безопасность работающего персонала и создать условия качественного выполнения работ: • все помещения должны иметь исправные • • лестницы, полы, освещение, вентиляцию; необходимо исключить возможность поражения электрическим током, паром и прочие) должно быть обеспечено сопровождение лиц, проводящих дератизацию и дезинсекцию следует обеспечить доступ лиц, проводящих дератизацию и дезинсекцию во все без исключения помещения и строения объекта, а также на прилегающую территорию

Область и условия применения средств дезинсекции • - Чрезвычайно опасные средства (I класса) • запрещаются для использования в закрытых помещениях Высокоопасные средства (II класса) запрещается использовать в детских, лечебно -профилактических организациях, на предприятиях общественного питания и в быту На других объектах допускается их применение только обученным персоналом в отсутствие людей с последующим обязательным проветриванием и уборкой

Область и условия применения средств дезинсекции • - Умеренно • • опасные средства (III класса) допускаются для использования как обученным персоналом в помещениях любого типа, так и населением в быту, но с обязательной регламентацией применения (расход препарата, режим проветривания, уборка) Малоопасные средства (IV класса) разрешаются для использования без ограничения сфер применения В соответствии со степенью опасности средств необходимо обращать внимание на специфику объекта (пищевые и другие организации)

Дезинсекция и дератизация • На время обработок удаляют из помещений • • людей После окончания дезинсекционных и дератизационных работ порошкообразные препараты через 24 часа удаляют с поверхностей, доступных людям и животным, в малодоступных местах дезсредства можно не убирать 1 месяц до потери ими эффективности Приманки, потерявшие активность, уничтожаются путем сжигания Затем поверхности моют водой с содой и мылом Помещения убирают при открытых форточках или окнах

Нормативные документы по профилактической дезинфекции • Инструкция 3. 5. 2. 10 22. 27 2005 • МЕТОДЫ ОПРЕДЕЛЕНИЯ ЭФФЕКТИВНОСТИ • • ИНСЕКТИЦИДОВ, РЕГУЛЯТОРОВ РАЗВИТИЯ, ИСПОЛЬЗУЕМЫХ В МЕДИЦИНСКОЙ ДЕЗИНСЕКЦИИ. ОЦЕНКА ДЕЗИНСЕКЦИОННЫХ СРЕДСТВ • В ПРАКТИЧЕСКИХ УСЛОВИЯХ • Инструкция 3. 5. 2. 10 22 34 2005 • НОРМАТИВНЫЕ ПОКАЗАТЕЛИ ЭФФЕКТИВНОСТИ ДЕЗИНСЕКЦИОННЫХ СРЕДСТВ

Нормативные документы по профилактической дезинфекции • Инструкция 3. 5. 10 22 53 2005 • ОБ ОРГАНИЗАЦИИ ПРОВЕДЕНИЯ И КОНТРОЛЕ ЭФФЕКТИВНОСТИ ДЕЗИНСЕКЦИОННЫХ, ДЕРАТИЗАЦИОННЫХ МЕРОПРИЯТИЙ • Инструкция 3. 5. 2. Ш 21 66 2005 • ЗАЩИТА НАСЕЛЕНИЯ ОТ ГНУСА И КЛЕЩЕЙ • Инструкция 3. 5. 2. 10 22 94 2005 • МЕТОДЫ БОРЬБЫ С СИНАНТРОПНЫМИ • НАСЕКОМЫМИ • Инструкция 3. 5. 3. 10 22 95 2005 МЕТОДЫ БОРЬБЫ С СИНАНТРОПНЫМИ ГРЫЗУНАМИ

Благодарю за внимание
дезинфекция на пищевом предп..ppt